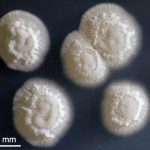

Ecco gli ultimi articoli pubblicati su MEDIA INAF
|
 |
RISULTATO STORICO PER L'INTERFEROMETRO EUROPEO
Ci sono candidati promettenti nel raccolto della prima battuta di caccia in tandem di Ligo e Virgo. Segnali visti da entrambi gli interferometri. Questo l'annuncio ufficiale apparso oggi in contemporanea sui siti delle due collaborazioni. Nessuna conferma, invece, circa i "rumors" che si susseguono da giorni su un "nuovo tipo" di onde gravitazionali
|
 |
CERCANDO TRACCE DI VITA NEL SISTEMA SOLARE
Tra le prime mansioni del James Webb Space Telescope, che verrà lanciato a ottobre 2018, ci sarà quella di osservare due tra le più interessanti lune del nostro Sistema solare: Europa ed Encelado. In orbita, rispettivamente, attorno a Giove e a Saturno, posseggono entrambe grandi oceani sotterranei: candidati ideali per la ricerca di forme di vita extraterrestre
|
 |
SCIAME METEORICO RITORNA DOPO 58 ANNI
Era il 1956 quando lo sciame delle Fenicidi ha fatto la loro prima apparizione. Poi nulla per decenni. Nel 2014 gli scienziati giapponesi sono riusciti a fotografarlo di nuovo e a capire la loro esatta provenienza
|
 |
VOCI E DOMANDE DELL'ASTROFISICA
Piccole come asteroidi, ma in grado di dare luogo alle più potenti esplosioni cosmiche conosciute. La densità all'interno di una stella di neutroni è tale che una zolletta di zucchero avrebbe una massa pari a quella di tutta l'umanità. Quando sono in coppia in sistemi binari emettono intense onde gravitazionali e, al momento della coalescenza, potrebbero dare origine ai Grb di 'tipo corto'
|
 |
RISOLTO ANNOSO MISTERO MATEMATICO
Il grande astronomo greco Ipparco probabilmente perde uno dei suoi primati, perché già i babilonesi 1500 anni prima avevano compilato una tabella trigonometrica, peraltro assolutamente precisa. Si tratta della tavoletta d'argilla con scrittura cuneiforme nota come Plimpton 322, analizzata da una coppia di matematici australiani
|
 |
LO SPETTACOLO SOLARE VISTO DA MOLTO VICINO
Gli strumenti del telescopio giapponese hanno regalato delle inedite immagini del raro fenomeno verificatosi lo scorso 21 agosto sopra gli Stati Uniti
|
 |
I RISULTATI SU ASTRONOMY & ASTROPHYSICS
I getti di plasma attorno ai resto di supernova della Vela sono molto frammentati, al punto da apparire come "shrapnel", le pallottole cave che all'esplosione vanno in mille pezzi. Un team internazionale del quale fanno parte tre ricercatori dell'Inaf di Palermo ne ha osservato uno con il telescopio spaziale Xmm-Newton, scoprendo un'insolita abbondanza di silicio
|
 |
NELLE ONDE GRAVITAZIONALI L'IMPRONTA DELLO SPIN
Esce oggi su "Nature" uno studio che rivela come i buchi neri in sistemi binari abbiano assi di rotazione non allineati, un dato da cui è possibile trarre preziose informazioni riguardo alla loro genesi. Media Inaf ha intervistato uno degli autori dell'articolo, il mantovano Alberto Vecchio, oggi astrofisico all'Università di Birmingham
|
|
È IN GRADO DI PRODURRE ANCHE LA PLASTICA
Una futura missione umana su Marte dovrebbe includere nel proprio bagaglio un particolare lievito. Non per fare il pane, o la birra, ma per trasformare l'urina e l'anidride carbonica prodotta dagli astronauti in Omega-3, nutrienti fondamentali, oppure ricavare plastica per stampare pezzi di ricambio in 3D
|
 |
VOYAGER IN SPACE, UN DOCU-FILM SULLA MISSIONE
Voyager. In una parola, due sonde e un'eccezionale avventura scientifica ai confini del Sistema solare. Una storia affascinante, quella degli esploratori automatici della Nasa, che è diventata un docu-film, in onda questa sera sul circuito statunitense Pbs
|
 |
IMMAGINI RARE: ECCO L'ATMOSFERA DI ANTARES
È l'immagine più dettagliata mai prodotta della superficie e dell'atmosfera di una stella. L'ha ottenuta, usando l'interferometro del Vlt dell'Eso, un team di astronomi guidato da Keiichi Ohnaka, dell'Universidad Católica del Norte in Cile. Con i dati raccolti, gli esperti hanno anche creato la prima mappa delle velocità del materiale che compone l'atmosfera stellare per una stella diversa dal Sole
|
Gli ultimi video e audio di MEDIA INAF
|
 |
25.08.2017
|
 |
24.08.2017
|
 |
23.08.2017
|
 |
23.08.2017
|
 |
|
Inoltre, sempre su Media Inaf puoi trovare:
|
|
È tutto, un saluto dalla redazione e buona lettura!
|
La redazione di Media Inaf invia la propria newsletter a :
CAPITAN FUTURO BLOG |
|
Nessun commento:
Posta un commento